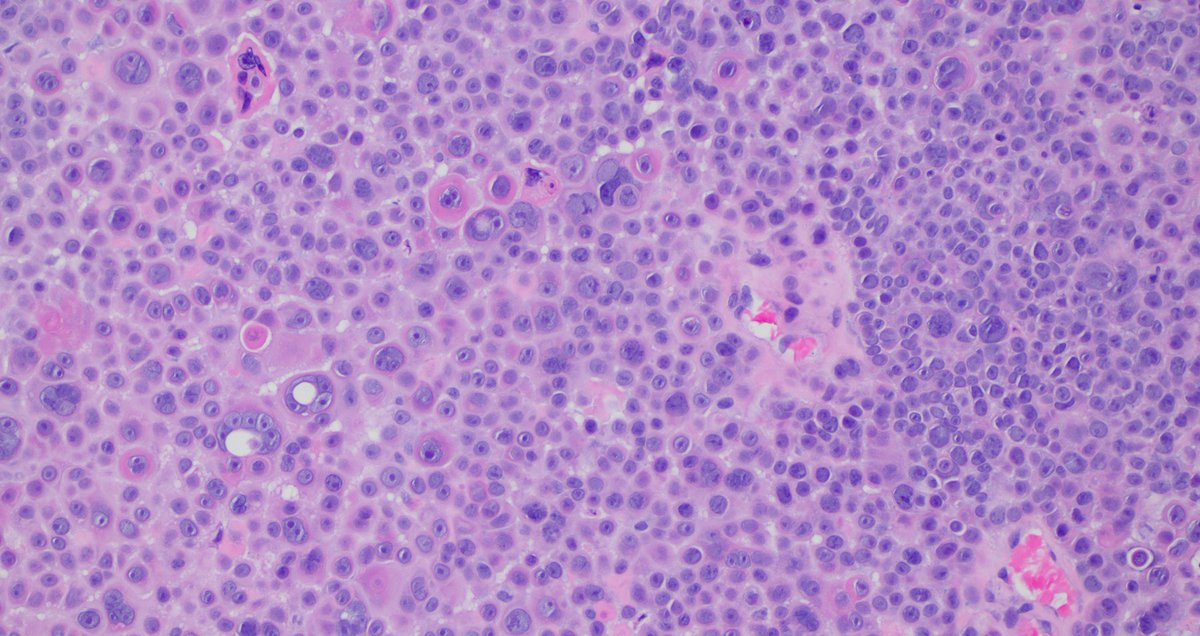
Signout Machine ⚙️ tweet media

Signout Machine ⚙️
8 posts

Signout Machine ⚙️
@signoutmachine
🌞 cytopathology 🌗 code
Katılım Ocak 2015
312 Takip Edilen64 Takipçiler

You can't find one much better than this! What is this structure called? What is the diagnosis? Answer & low power pic: kikoxp.com/posts/10640. Video: kikoxp.com/posts/4376. #pathology #pathologists #pathTwitter #dermpath #dermatology #dermatologia #dermtwitter

English



@dgbrackett I mostly use these 2 books from @LizMontgomeryMD
amazon.com/Biopsy-Interpr…
amazon.com/Atlas-Gastroin…
English

Your favorite resources for the nitty-gritty details of non-neoplastic GI biopsies? Go.
#GIpath
English